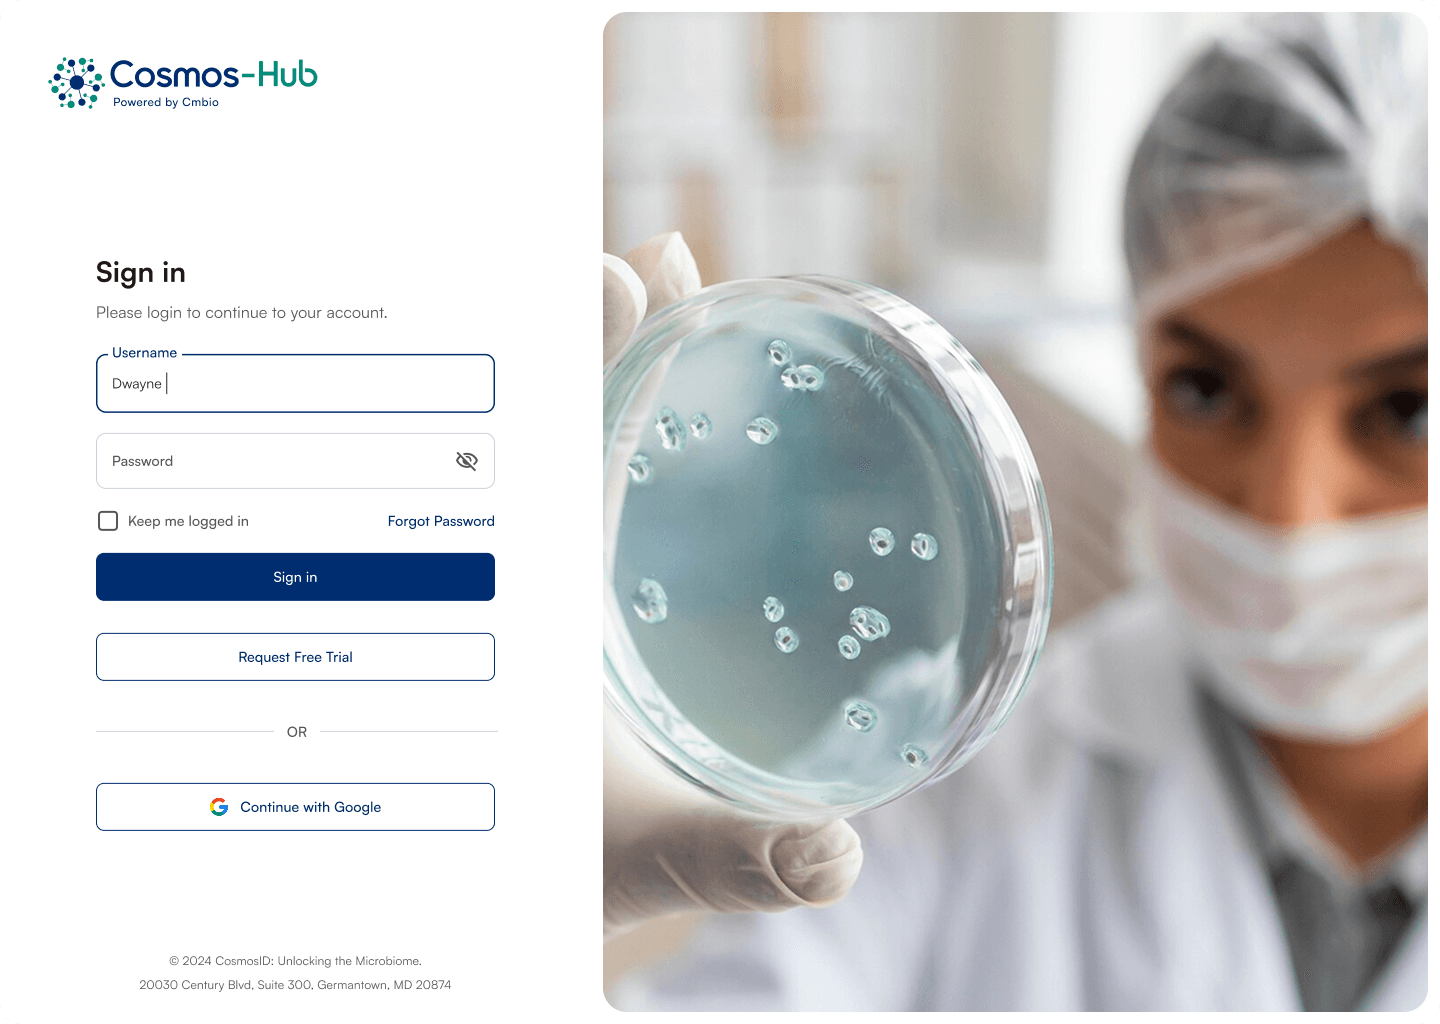
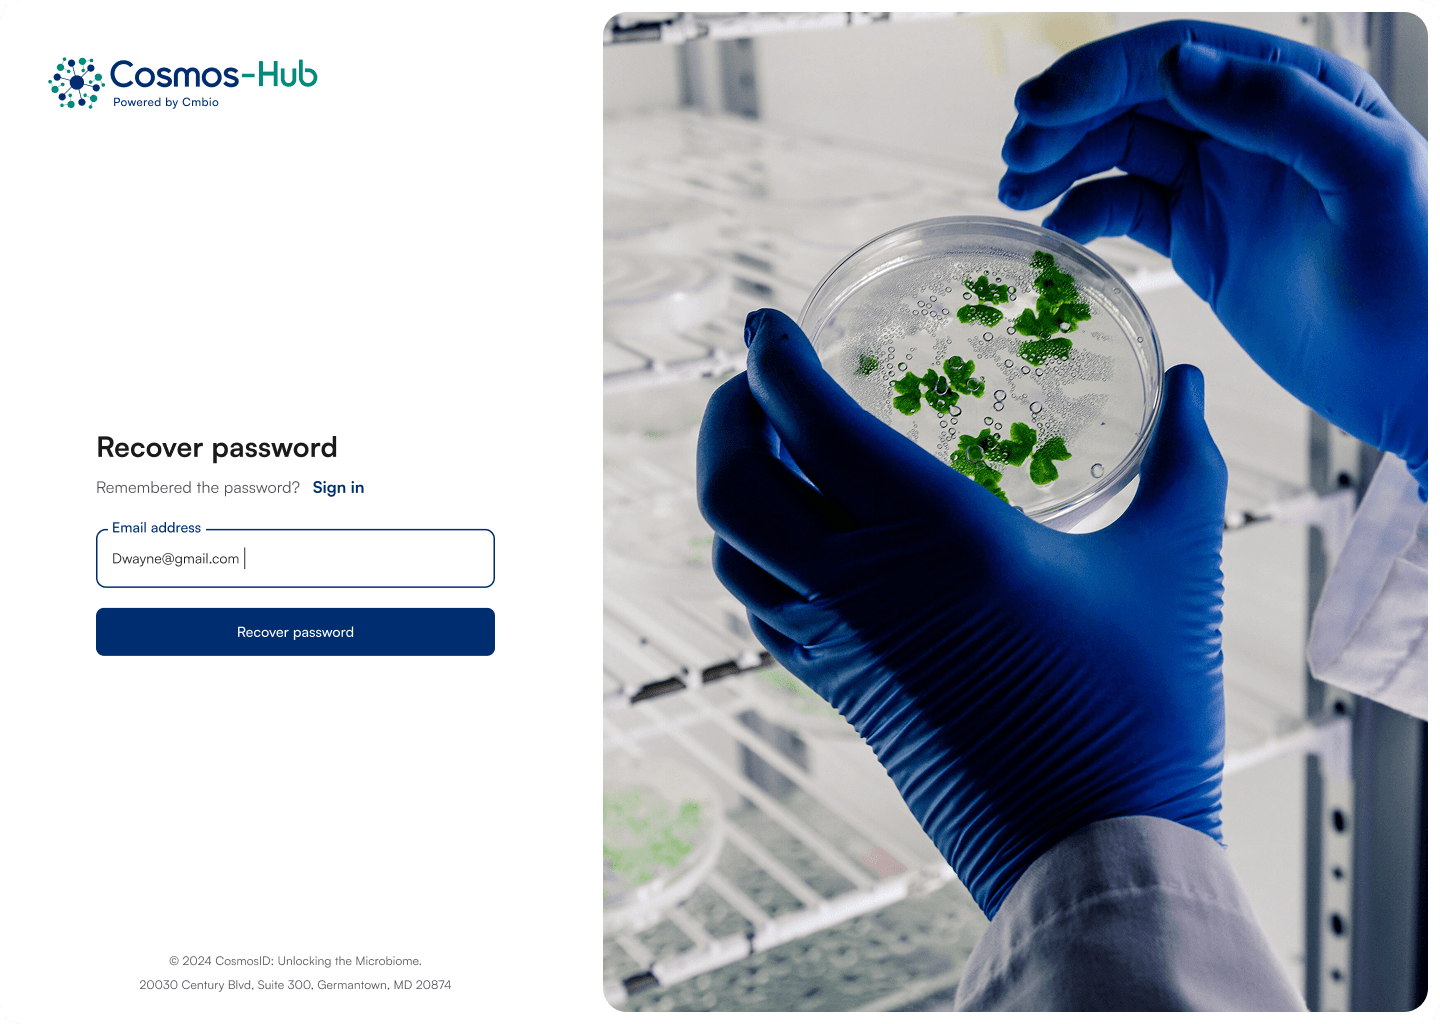

DISCOVER PROJECT
CosmosID / Nayeim Khan
Cosmos Hub
AI-powered microbiome intelligence platform transforming complex bio-data into clear insights.
2025
Cosmos Hub is a data driven platform built for researchers working with microbiome datasets. The challenge was simplifying highly technical biological data into a clear and structured digital interface. The goal was to design dashboards that help scientists explore and interpret complex data without unnecessary visual complexity.
LEAD UI/UX DESIGNER RESPONSIBLE FOR DASHBOARD ARCHITECTURE, DATA VISUALIZATION STRUCTURE, AND DESIGN SYSTEM DEVELOPMENT USING FIGMA AND FIGJAM.

Process
The project followed a collaborative design process including research, workflow mapping, interface design, and continuous feedback with domain experts and developers.
I began by mapping user journeys for researchers and analysts to understand how microbiome data is explored and interpreted. Wireframes were used to simplify complex screens before developing high-fidelity dashboard layouts using a consistent design system.


Good design should make complex systems understandable. Cosmos Hub focuses on clarity and structure, helping researchers interpret scientific data quickly while maintaining the depth required for advanced analysis.
Final Design
The final design delivers a modular dashboard system that presents microbiome data in a clean and structured format. Clear hierarchy, spacing, and reusable components help researchers analyze complex datasets more efficiently.
The interface supports scalable workflows, allowing the platform to expand as new scientific tools and analysis modules are introduced.
Product Images




Designing Cosmos Hub strengthened my ability to simplify highly technical systems into clear and scalable digital products. The project demonstrates how thoughtful UX design can transform complex scientific tools into accessible platforms.
Achievements
“The redesigned Cosmos Hub interface significantly improved clarity when working with complex datasets. The structured layout helped our team focus on insights instead of navigating through clutter.”
Product Lead, CosmosID
Cosmos Hub improved microbiome data usability by organizing complex workflows into a structured digital platform.
Workflow Efficiency
User Satisfaction




